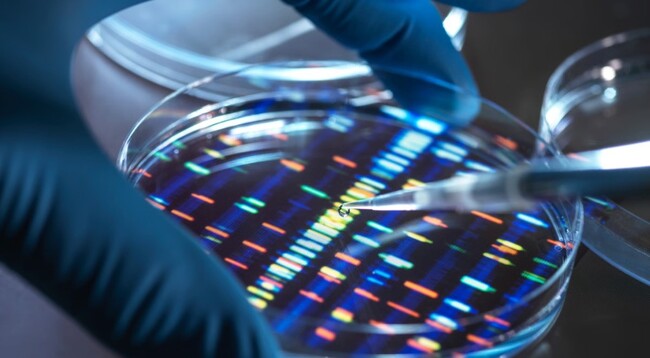

کاربران کیف پول دیجیتال Trust Wallet مدت کوتاهی بعد از [...]
به گزارش خبرآنلاین، به نقل از دیجیاتو، در جریان رقابتهای امنیتی [...]
به گزارش خبرگزاری خبرآنلاین و براساس گزارش زومیت، افلاک (Aflac)، غول [...]
به گزارش خبرگزاری خبرآنلاین و به نقل از دیجیاتو، شرکت Discord [...]
هکرها حالا بدافزارها را در فایلهای تصویری با فرمت SVG [...]
«با یک تماس ساده از طریق واتساپ، گوشی قابل هک [...]
علیرغم پیشرفت فناوریهای امنیت سایبری، حملات سایبری علیه پلتفرمهای موبایل، [...]
به گزارش اقتصادآنلاین به نقل از فارس؛ شرکت «آرکام اینتلجنس»، [...]
در این ایام بسیاری از افراد بیشتر به امنیت گوشی [...]
جاسوسافزارها بهصورت پنهانی تمامی فعالیتهای شما را در دستگاه، از [...]
متیو دی لین، دانشجوی ۱۹ ساله دانشگاه Assumption در ماساچوست، [...]
دانشمندان در تازهترین پژوهشها نشان دادهاند که تکنولوژیهای پیشرفتهای مانند [...]
مجموعهای از اطلاعات حساس مربوط به حدود 30 میلیون مشترک [...]